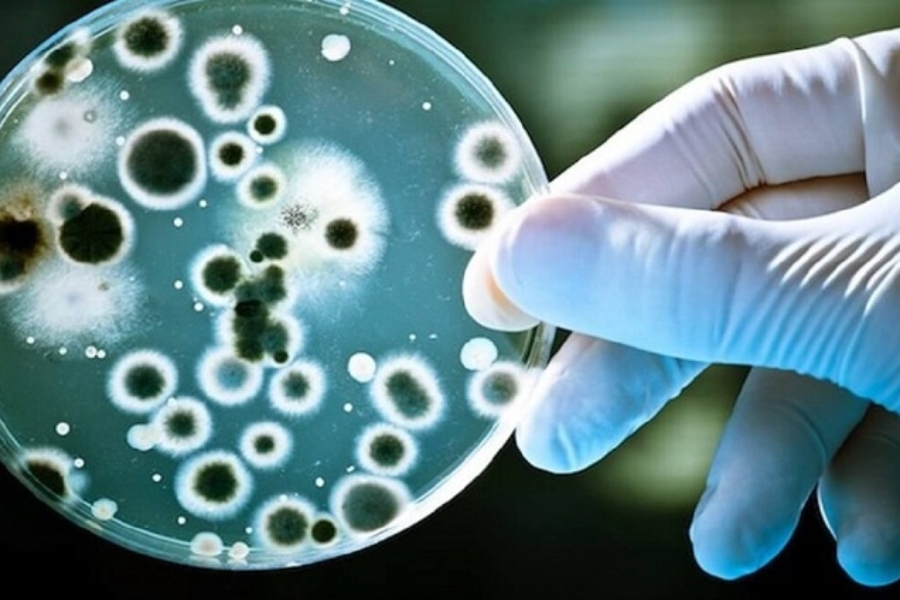
tre-bi-tieu-chay-cap-4

Trẻ bị tiêu chảy cấp là tình trạng phổ biến, đặc biệt ở bé 6 tháng – 3 tuổi. Dù đa phần tự khỏi, nhưng nếu không xử trí đúng, tiêu chảy cấp ở trẻ có thể gây mất nước nghiêm trọng, đe dọa tính mạng. Bài viết này sẽ giúp cha mẹ hiểu rõ nguyên nhân, dấu hiệu và cách xử trí hiệu quả khi trẻ bị tiêu chảy cấp, bảo vệ bé an toàn.
1. Tiêu chảy cấp ở trẻ là gì?
Tiêu chảy cấp là tình trạng trẻ đi ngoài phân lỏng, nhiều nước với tần suất nhiều hơn bình thường (trên 3 lần/ngày), kéo dài trong vài ngày đến một tuần. Tình trạng này xuất hiện đột ngột, thường do nhiễm trùng đường tiêu hóa hoặc các yếu tố khác ảnh hưởng đến hệ tiêu hóa của bé.
Dựa trên thời gian kéo dài, tiêu chảy được chia làm 3 loại:
- Tiêu chảy cấp tính: kéo dài dưới 7 ngày.
- Tiêu chảy bán cấp: kéo dài từ 7 đến 21 ngày.
- Tiêu chảy mạn tính: kéo dài trên 4 tuần.
Trong đó, tiêu chảy cấp là dạng thường gặp nhất, nhưng cũng tiềm ẩn nguy cơ mất nước nghiêm trọng, đặc biệt với trẻ dưới 3 tuổi.
Tiêu chảy cấp là tình trạng trẻ đi ngoài phân lỏng, nhiều nước kéo dài dưới 7 ngày
2. Nguyên nhân thường gặp khiến trẻ bị tiêu chảy cấp
Để điều trị tiêu chảy cấp ở trẻ một cách chính xác, việc xác định nguyên nhân là then chốt. Dưới đây là một số nguyên nhân phổ biến:
2.1 Tiêu chảy do Rotavirus
Rotavirus là nguyên nhân hàng đầu gây tiêu chảy cấp ở trẻ nhỏ và cũng là nguyên nhân gây tử vong chính trong nhóm tiêu chảy do virus. Virus này chủ yếu gây bệnh cho trẻ em dưới 3 tuổi. Khi xâm nhập theo đường tiêu hóa, Rotavirus gây tổn thương và phá hủy chọn lọc các tế bào trụ của niêm mạc ruột non. Điều này dẫn đến hạn chế khả năng hấp thu nước, muối, và kéo nước từ các tổ chức tế bào vào lòng ruột. Đồng thời, quá trình hấp thu đường và chất béo cũng bị giảm sút, gây rối loạn tiêu hóa mỡ, khiến trẻ mất nước, điện giải và suy dinh dưỡng nhanh chóng.
Trẻ bị tiêu chảy cấp do Rotavirus thường khởi phát đột ngột với các triệu chứng điển hình:
- Sốt (có thể cao hoặc không sốt).
- Nôn nhiều.
- Tiêu chảy nhiều lần trong ngày, phân rất nhiều nước.
- Tình trạng mất nước điện giải có thể diễn ra rất nhanh.
Cách điều trị: Chủ yếu là điều chỉnh cân bằng nước và điện giải cho trẻ một cách kịp thời và liên tục, bởi hiện tại chưa có thuốc điều trị đặc hiệu cho virus Rotavirus. Việc bù nước và điện giải đúng cách là yếu tố sống còn để cứu sống trẻ.
2.2. Tiêu chảy do vi khuẩn Salmonella
Vi khuẩn Salmonella thường cư trú trong thịt, trứng, sữa và có khả năng sinh sôi mà không làm thay đổi màu sắc, mùi vị của thực phẩm, khiến việc nhận biết trở nên khó khăn.
Khi trẻ bị tiêu chảy cấp do nhiễm Salmonella, sau khoảng 12 – 36 giờ ủ bệnh, trẻ sẽ xuất hiện các triệu chứng cấp tính như:
- Đau bụng dữ dội.
- Buồn nôn và nôn nhiều lần.
- Sốt cao, rét run, nhức đầu, mệt mỏi.
- Đi ngoài nhiều lần trong ngày, phân thối, nhiều nước, không có cảm giác mót rặn. Đôi khi trong phân có thể lẫn thức ăn chưa tiêu hóa hết.
Nếu không được điều trị kịp thời, tình trạng này có thể dẫn đến thiểu niệu, vô niệu và nguy hiểm nhất là tử vong do rối loạn nước và điện giải nghiêm trọng.
Cách điều trị: Chủ yếu là bù nước và điện giải tích cực để chống mất nước, kết hợp hạ sốt. Trong những trường hợp nặng hơn, bác sĩ có thể cân nhắc chỉ định thêm thuốc kháng sinh và thuốc an thần để kiểm soát triệu chứng.
Vi khuẩn Salmonella trong thực phẩm có thể gây tiêu chảy cho trẻ
2.3 Tiêu chảy do tụ cầu vàng
Ngoại độc tố của tụ cầu vàng là tác nhân gây bệnh chính trong trường hợp này. Sau khi xâm nhập vào đường tiêu hóa qua thức ăn, các độc tố này không bị men tiêu hóa phân hủy mà nhanh chóng thấm vào niêm mạc dạ dày, ruột và máu, tác động lên hệ thần kinh thực vật gây cường phó giao cảm, có thể dẫn đến trụy tim mạch.
Sau khi nhiễm từ 30 phút đến 6 giờ, trẻ bị tiêu chảy cấp do tụ cầu vàng sẽ có các biểu hiện khởi phát đột ngột:
- Đau bụng dữ dội, quặn từng cơn, thường tập trung ở vùng thượng vị nhiều hơn vùng rốn.
- Buồn nôn và nôn nhiều lần, thường xảy ra trước khi đi ngoài.
- Đi ngoài nhiều lần trong ngày, phân rất nhiều nước.
- Trẻ thường không sốt hoặc chỉ sốt nhẹ, kèm theo nhức đầu, mệt mỏi.
- Nguy cơ rối loạn nước và điện giải, có thể dẫn đến trụy tim mạch.
Trường hợp tử vong thường chỉ xảy ra ở trẻ nhỏ hoặc người già có sức đề kháng suy kiệt.
Cách điều trị: Trọng tâm là bù nước và điện giải cấp tốc, cùng với các biện pháp hỗ trợ tim mạch nếu cần thiết.
Ngoài các tác nhân thông thường, trẻ bị tiêu chảy cấp còn có thể do nhiễm trùng ngoài ruột (như viêm hô hấp, tiết niệu, sởi, tay chân miệng). Bên cạnh đó, dị ứng thức ăn (sữa bò, lạc), tác dụng phụ của thuốc (kháng sinh, nhuận tràng), hóa trị, xạ trị, rối loạn tiêu hóa/hấp thu, suy giảm miễn dịch, thiếu vitamin hoặc một số bệnh lý ngoại khoa cũng là những nguyên nhân tiềm ẩn.
Tụ cầu vàng xâm nhập vào hệ tiêu hoá của trẻ gây tiêu chảy
3. Hướng dẫn xử trí khi trẻ bị tiêu chảy cấp tại nhà
Khi trẻ bị tiêu chảy cấp, việc xử trí đúng và kịp thời ngay tại nhà có thể giúp giảm nguy cơ mất nước, hạn chế biến chứng và rút ngắn thời gian hồi phục. Dưới đây là các bước xử trí khoa học, được khuyến nghị bởi chuyên gia nhi khoa:
3.1 Bù nước và điện giải đúng cách
Bù nước và điện giải là nguyên tắc nền tảng trong điều trị tiêu chảy, đặc biệt khi trẻ bị tiêu chảy cấp do virus hoặc vi khuẩn.
- Sử dụng ORS (Oresol) theo đúng hướng dẫn: Pha theo đúng tỷ lệ (1 gói với 200ml hoặc 1 lít nước, tùy loại), không pha đặc, không pha với nước trái cây hay nước có gas.
- Cho trẻ uống từng ngụm nhỏ bằng thìa hoặc muỗng nhỏ, tránh ép uống quá nhanh.
- Liều khuyến cáo sau mỗi lần đi ngoài:
- Trẻ dưới 2 tuổi: 50–100ml/lần
- Trẻ 2–10 tuổi: 100–200ml/lần
- Trẻ lớn hơn: uống theo nhu cầu
Ngoài oresol, có thể dùng nước cháo loãng, nước canh rau củ, nước dừa – nhưng không thay thế hoàn toàn cho ORS.
3.2 Duy trì chế độ ăn uống đầy đủ
Một trong những sai lầm phổ biến khi trẻ bị tiêu chảy cấp là ngưng cho ăn hoặc chỉ cho uống nước lọc, khiến trẻ dễ suy dinh dưỡng và phục hồi chậm.
- Tiếp tục cho trẻ bú mẹ hoàn toàn hoặc uống sữa như bình thường.
- Với trẻ ăn dặm:
- Ưu tiên thức ăn mềm, dễ tiêu như cháo thịt bằm, súp gà, cơm nhão.
- Cho trẻ ăn nhiều bữa nhỏ trong ngày.
- Bổ sung thực phẩm giàu kali (chuối, khoai), natri (nước canh, súp), chất xơ hòa tan (bí đỏ, táo hấp, bột yến mạch).
- Tránh thực phẩm nhiều đường, béo, sữa bò (nếu không dung nạp), đồ uống có gas, cà phê, trà, thực phẩm sống/để nguội.
3.3 Dùng men vi sinh hỗ trợ điều trị
Đối với trẻ bị tiêu chảy cấp, bổ sung men vi sinh giúp rút ngắn thời gian bệnh, cải thiện hấp thu, đặc biệt khi tiêu chảy liên quan đến mất cân bằng hệ vi sinh đường ruột (sau dùng kháng sinh, nhiễm khuẩn…).
- Nên chọn các loại men chứa: Lactobacillus GG, Bifidobacterium, Saccharomyces boulardii
- Có thể kết hợp với chất xơ hòa tan (prebiotic) như FOS, inulin.
- Cho trẻ uống sau bữa ăn, ngày 1–2 lần theo hướng dẫn.
Lưu ý: Men vi sinh không thay thế thuốc điều trị hay dung dịch ORS.
Bổ sung men vi sinh hỗ trợ cải thiện tiêu chảy
3.4 Theo dõi dấu hiệu mất nước và biến chứng
Cha mẹ cần theo dõi sát để phát hiện sớm các dấu hiệu mất nước ở trẻ bị tiêu chảy cấp:
- Trẻ mệt mỏi, li bì, da nhăn, mắt trũng, môi khô.
- Trẻ tiểu ít, khóc không ra nước mắt.
- Sốt cao > 38.5°C, nôn nhiều, không uống được.
- Phân có máu, mùi thối bất thường hoặc màu đen.
Khi có dấu hiệu nặng, cần đưa trẻ đến cơ sở y tế ngay để được thăm khám và điều trị kịp thời.
3.5 Vệ sinh chăm sóc trẻ đúng cách
Để giúp trẻ bị tiêu chảy cấp phục hồi nhanh và hạn chế nguy cơ tái nhiễm, cha mẹ cần chú ý:
- Thay tã thường xuyên, vệ sinh vùng hậu môn bằng nước ấm sau mỗi lần đi ngoài.
- Dùng khăn sạch, mềm để lau khô, tránh gây hăm hoặc viêm da.
- Rửa tay sạch cho người chăm sóc trước và sau khi xử lý chất thải của trẻ.
- Khử trùng đồ chơi, vật dụng trẻ tiếp xúc mỗi ngày.
3.6 Không tự ý dùng thuốc cầm tiêu chảy
Nhiều phụ huynh lo lắng khi trẻ bị tiêu chảy cấp và tìm cách dùng thuốc cầm tiêu chảy. Tuy nhiên:
- Không được dùng thuốc làm chậm nhu động ruột cho trẻ nhỏ (như Loperamide) vì có thể giữ độc tố trong ruột, khiến bệnh nặng hơn.
- Chỉ dùng kháng sinh khi có chỉ định của bác sĩ, đặc biệt nếu tiêu chảy có máu, sốt cao, nghi nhiễm khuẩn nặng.
Trẻ bị tiêu chảy cấp là tình trạng thường gặp, đặc biệt trong giai đoạn bé bắt đầu ăn dặm. Tuy nhiên, nếu không chăm sóc đúng cách, bệnh có thể dẫn tới mất nước và rối loạn điện giải nguy hiểm. Cha mẹ cần trang bị kiến thức để nhận biết sớm, xử trí đúng và phòng ngừa hiệu quả. Khi có dấu hiệu bất thường, nên đưa trẻ đến cơ sở y tế uy tín để được bác sĩ đánh giá và điều trị kịp thời.